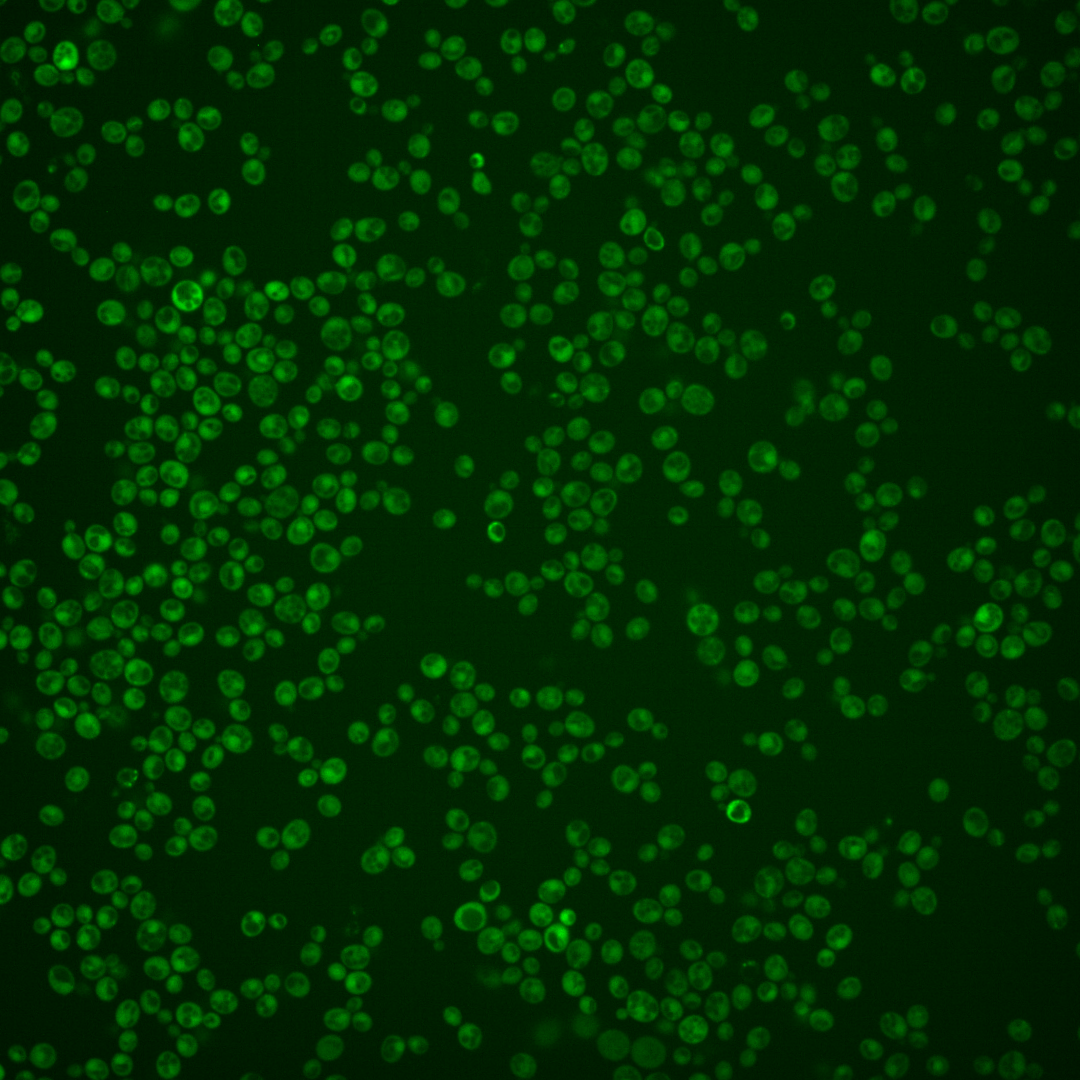
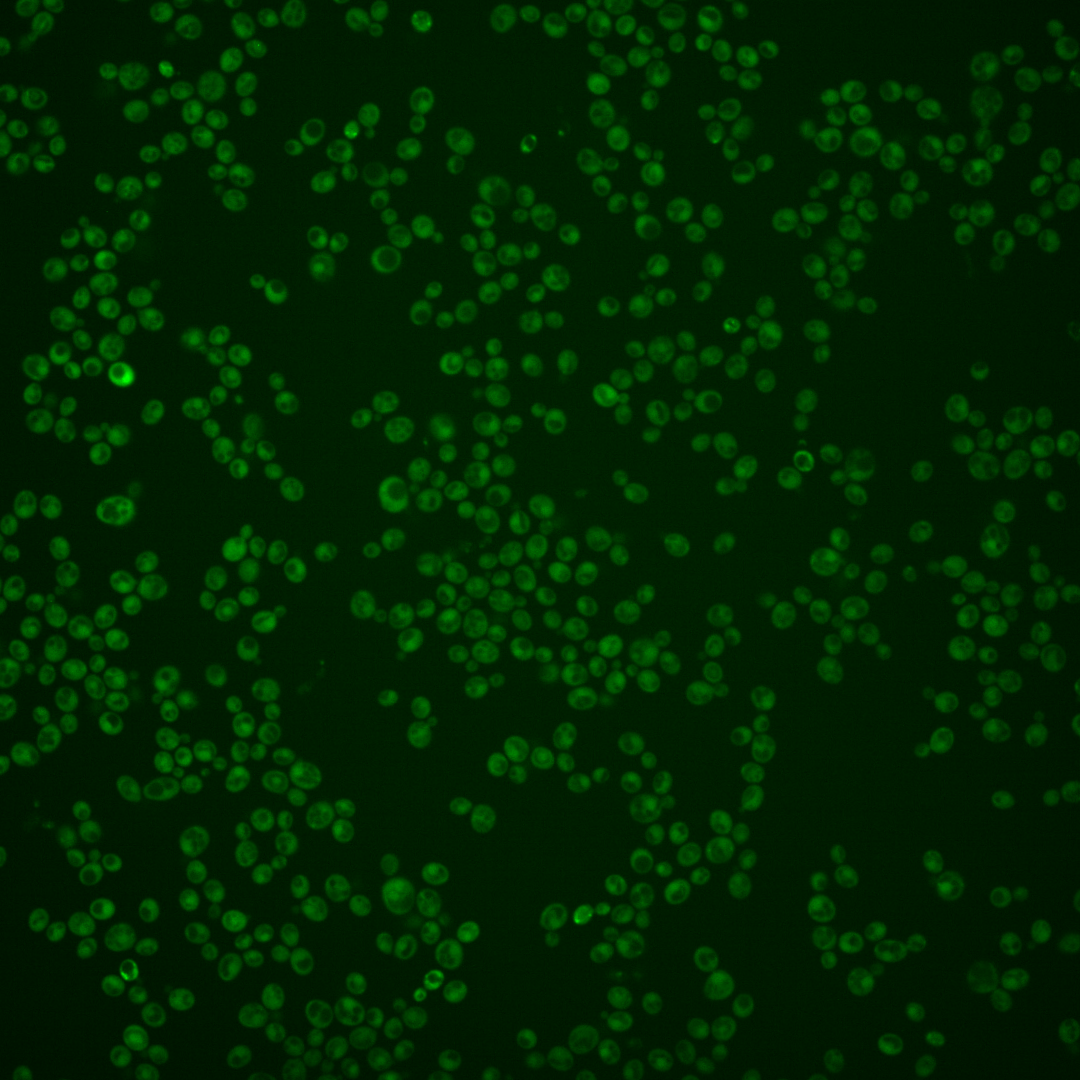
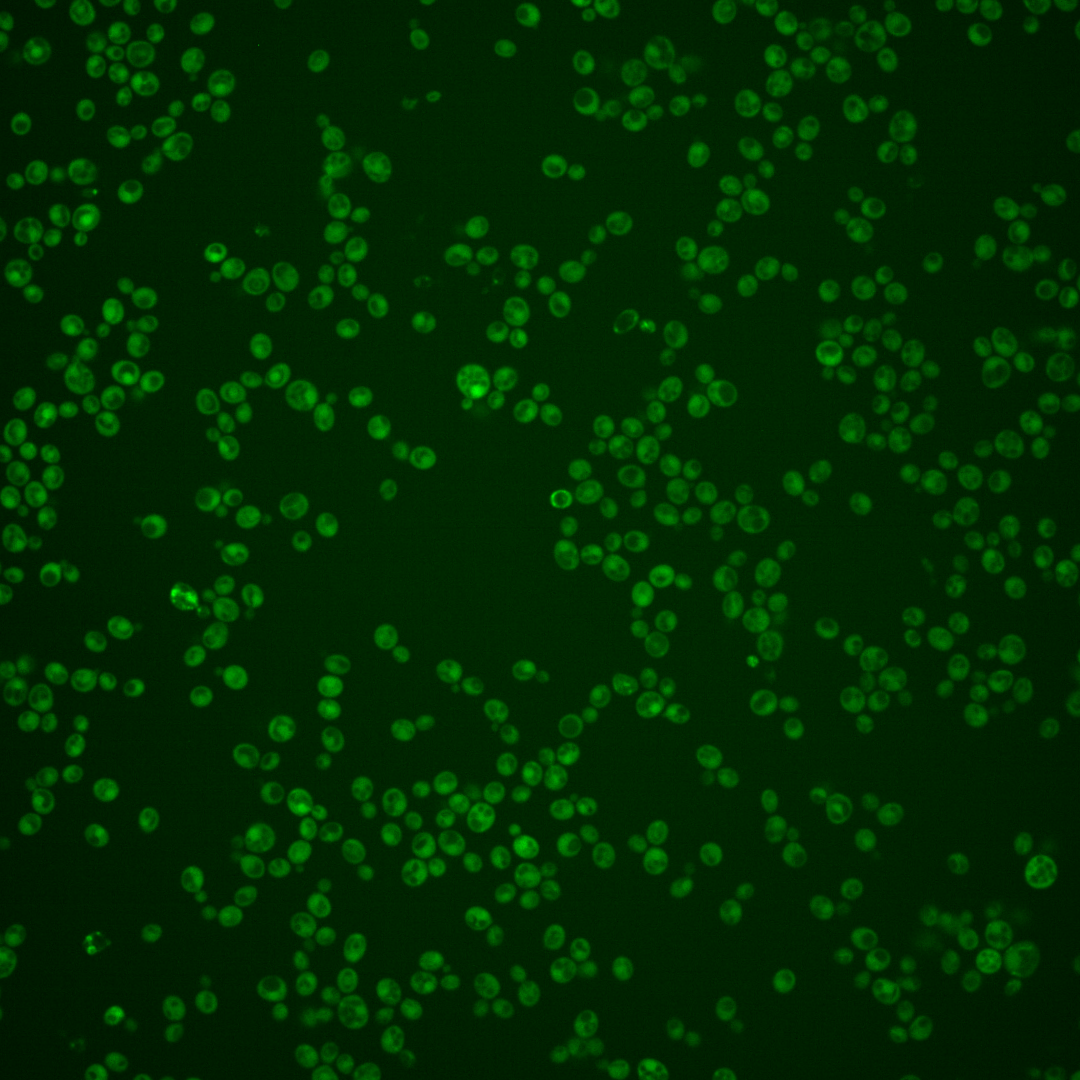
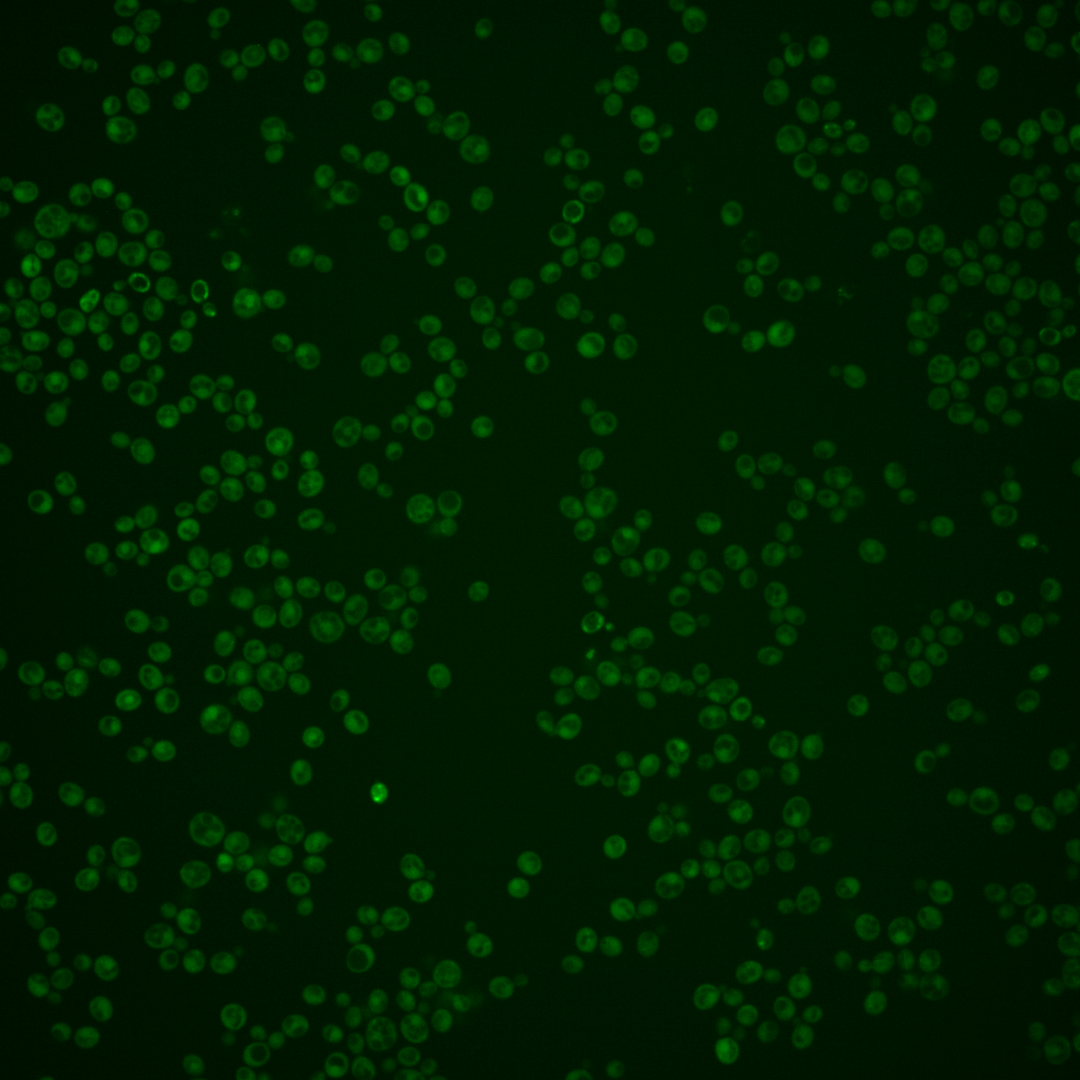

| Standard name | |
|---|---|
| Human Ortholog | |
| Description | Type II nitroreductase, using NADH as reductant; mutants are defective in fatty acid mediated repression of genes involved in fatty acid biosynthesis indicative of a role in lipid signaling; involved in the oxidative stress response; transcription induction by cadmium and selenite indicates a possible role in the metal stress response; expression induced in cells treated with the mycotoxin patulin |
Micrographs




















































































Sub-cellular Localization
Yeast GFP Assignment
Protein Abundance
Localization Change
External localization resources
| ensLOC | DeepLoc | |||||||||||||||||||||||
|---|---|---|---|---|---|---|---|---|---|---|---|---|---|---|---|---|---|---|---|---|---|---|---|---|
| Localization | WT1 | WT2 | WT3 | RAP60 | RAP140 | RAP220 | RAP300 | RAP380 | RAP460 | RAP540 | RAP620 | RAP700 | HU80 | HU120 | HU160 | rpd3Δ_1 | rpd3Δ_2 | rpd3Δ_3 | WT1 | WT2 | WT3 | AF100 | AF140 | AF180 |
| Cortical Patches | 0 | 0 | 0 | 0 | 0 | 0 | 0 | – | 1 | 0 | 0 | 0 | 1 | 0 | 0 | – | 0 | – | 1 | 1 | 1 | 1 | 6 | 4 |
| Bud | 0 | 2 | 0 | 3 | 0 | 1 | 3 | – | 5 | 5 | 6 | 5 | 0 | 0 | 0 | – | 0 | – | 1 | 0 | 1 | 2 | 12 | 7 |
| Bud Neck | 1 | 0 | 2 | 4 | 5 | 7 | 17 | – | 12 | 15 | 9 | 8 | 1 | 0 | 0 | – | 2 | – | 0 | 0 | 0 | 0 | 1 | 4 |
| Bud Site | 0 | 0 | 0 | 0 | 0 | 0 | 0 | – | 0 | 0 | 4 | 3 | 1 | 0 | 0 | – | 0 | – | – | – | – | – | – | – |
| Cell Periphery | 2 | 0 | 3 | 2 | 1 | 0 | 1 | – | 1 | 1 | 0 | 2 | 1 | 2 | 1 | – | 5 | – | 1 | 0 | 0 | 0 | 2 | 2 |
| Cytoplasm | 175 | 107 | 56 | 184 | 263 | 187 | 465 | – | 256 | 386 | 212 | 341 | 352 | 436 | 464 | – | 207 | – | 158 | 98 | 69 | 198 | 383 | 275 |
| Endoplasmic Reticulum | 1 | 1 | 0 | 0 | 0 | 3 | 0 | – | 0 | 1 | 0 | 0 | 0 | 1 | 0 | – | 15 | – | 0 | 0 | 1 | 1 | 4 | 0 |
| Endosome | 1 | 0 | 0 | 0 | 0 | 0 | 3 | – | 1 | 1 | 0 | 0 | 0 | 0 | 1 | – | 2 | – | 2 | 1 | 0 | 0 | 5 | 6 |
| Golgi | 0 | 1 | 0 | 0 | 0 | 0 | 0 | – | 0 | 0 | 0 | 0 | 0 | 0 | 0 | – | 3 | – | 0 | 2 | 0 | 0 | 1 | 0 |
| Mitochondria | 8 | 15 | 1 | 8 | 0 | 24 | 30 | – | 61 | 79 | 93 | 106 | 1 | 1 | 1 | – | 3 | – | 11 | 6 | 8 | 9 | 29 | 29 |
| Nucleus | 0 | 0 | 1 | 0 | 2 | 5 | 2 | – | 2 | 2 | 3 | 4 | 0 | 1 | 1 | – | 0 | – | 0 | 0 | 0 | 0 | 0 | 0 |
| Nuclear Periphery | 0 | 0 | 0 | 0 | 0 | 0 | 1 | – | 0 | 0 | 0 | 3 | 0 | 0 | 0 | – | 0 | – | 0 | 0 | 0 | 0 | 0 | 3 |
| Nucleolus | 0 | 1 | 0 | 0 | 0 | 0 | 0 | – | 0 | 0 | 0 | 1 | 0 | 0 | 0 | – | 1 | – | 0 | 0 | 0 | 0 | 0 | 0 |
| Peroxisomes | 0 | 0 | 0 | 0 | 0 | 0 | 0 | – | 0 | 0 | 0 | 0 | 0 | 0 | 0 | – | 2 | – | 0 | 0 | 0 | 0 | 1 | 0 |
| SpindlePole | 0 | 0 | 0 | 0 | 1 | 2 | 22 | – | 4 | 15 | 4 | 12 | 0 | 0 | 0 | – | 0 | – | 2 | 0 | 0 | 3 | 11 | 4 |
| Vac/Vac Membrane | 3 | 1 | 0 | 2 | 1 | 0 | 2 | – | 0 | 2 | 0 | 5 | 0 | 0 | 5 | – | 5 | – | 1 | 1 | 0 | 1 | 2 | 3 |
| Unique Cell Count | 183 | 113 | 57 | 191 | 266 | 205 | 498 | 300 | 442 | 277 | 421 | 354 | 438 | 468 | 220 | 189 | 116 | 89 | 225 | 474 | 353 | |||
| Labelled Cell Count | 191 | 128 | 63 | 203 | 273 | 229 | 546 | 343 | 507 | 331 | 490 | 357 | 441 | 473 | 245 | 189 | 116 | 89 | 225 | 474 | 353 | |||
Yeast GFP Assignment
Protein Abundance
| Screen | WT1 | WT2 | WT3 | RAP60 | RAP140 | RAP220 | RAP300 | RAP380 | RAP460 | RAP540 | RAP620 | RAP700 | HU80 | HU120 | HU160 | rpd3Δ_1 | rpd3Δ_2 | rpd3Δ_3 | AF100 | AF140 | AF180 |
|---|---|---|---|---|---|---|---|---|---|---|---|---|---|---|---|---|---|---|---|---|---|
| Mean Cell GFP Intensity (1e-4) | 3.7 | 3.8 | 4.5 | 4.6 | 5.1 | 3.3 | 4.0 | – | 3.5 | 3.6 | 3.5 | 3.3 | 4.6 | 4.9 | 5.2 | 4.9 | 5.1 | 4.8 | 4.3 | 4.2 | 4.5 |
| Std Deviation (1e-4) | 0.8 | 0.9 | 0.7 | 2.0 | 1.5 | 1.0 | 1.2 | – | 1.4 | 1.1 | 1.3 | 1.0 | 1.6 | 1.8 | 2.0 | 1.2 | 1.2 | 0.8 | 2.0 | 1.7 | 2.0 |
| Intensity Change (Log2) | – | – | – | 0.03 | 0.18 | -0.46 | -0.18 | – | -0.35 | -0.34 | -0.38 | -0.42 | 0.05 | 0.12 | 0.22 | 0.12 | 0.19 | 0.09 | -0.08 | -0.09 | -0.0 |
Localization Change
| Localization | RAP60 | RAP140 | RAP220 | RAP300 | RAP380 | RAP460 | RAP540 | RAP620 | RAP700 | HU80 | HU120 | HU160 | rpd3Δ_1 | rpd3Δ_2 | rpd3Δ_3 |
|---|---|---|---|---|---|---|---|---|---|---|---|---|---|---|---|
| Actin | – | – | – | – | – | – | – | – | – | – | – | – | – | – | – |
| Bud | – | – | – | – | – | – | – | – | – | – | – | – | – | – | – |
| Bud Neck | – | – | – | – | – | – | – | – | – | – | – | – | – | – | – |
| Bud Site | – | – | – | – | – | – | – | – | – | – | – | – | – | – | – |
| Cell Periphery | – | – | – | – | – | – | – | – | – | – | – | – | – | – | – |
| Cyto | – | – | – | – | – | – | – | – | – | – | – | – | – | – | – |
| Endoplasmic Reticulum | – | – | – | – | – | – | – | – | – | – | – | – | – | – | – |
| Endosome | – | – | – | – | – | – | – | – | – | – | – | – | – | – | – |
| Golgi | – | – | – | – | – | – | – | – | – | – | – | – | – | – | – |
| Mitochondria | – | – | – | – | – | – | – | – | – | – | – | – | – | – | – |
| Nuclear Periphery | – | – | – | – | – | – | – | – | – | – | – | – | – | – | – |
| Nuc | – | – | – | – | – | – | – | – | – | – | – | – | – | – | – |
| Nucleolus | – | – | – | – | – | – | – | – | – | – | – | – | – | – | – |
| Peroxisomes | – | – | – | – | – | – | – | – | – | – | – | – | – | – | – |
| SpindlePole | – | – | – | – | – | – | – | – | – | – | – | – | – | – | – |
| Vac | – | – | – | – | – | – | – | – | – | – | – | – | – | – | – |
| Cortical Patches | – | – | – | – | – | – | – | – | – | – | – | – | – | – | – |
| Cytoplasm | – | – | – | – | – | – | – | – | – | – | – | – | – | – | – |
| Nucleus | – | – | – | – | – | – | – | – | – | – | – | – | – | – | – |
| Vacuole | – | – | – | – | – | – | – | – | – | – | – | – | – | – | – |
External localization resources
Images






























Protein Concentration and Protein Localization Data
| R1 | R2 | R3 | ||||||||||||||||
|---|---|---|---|---|---|---|---|---|---|---|---|---|---|---|---|---|---|---|
| G1 Pre-START | G1 Post-START | S/G2 | Metaphase | Anaphase | Telophase | G1 Pre-START | G1 Post-START | S/G2 | Metaphase | Anaphase | Telophase | G1 Pre-START | G1 Post-START | S/G2 | Metaphase | Anaphase | Telophase | |
| Concentration | 1.2829 | 2.7372 | 2.2573 | 0.5807 | 1.6815 | 1.9968 | 1.6469 | 2.9782 | 2.971 | 3.4317 | 0.6657 | 3.5947 | 3.2054 | 4.8888 | 4.3373 | 2.0888 | 4.2855 | 5.6937 |
| Actin | 0.0167 | 0.0012 | 0.0031 | 0.0609 | 0.0006 | 0.0018 | 0.0158 | 0.0003 | 0.0062 | 0.0051 | 0.0212 | 0.0239 | 0.0498 | 0.001 | 0.0094 | 0.0064 | 0.0221 | 0.0044 |
| Bud | 0.0015 | 0.0042 | 0.0057 | 0.0009 | 0.0043 | 0.0005 | 0.0012 | 0.0035 | 0.002 | 0.0003 | 0.0043 | 0.0005 | 0.0014 | 0.0032 | 0.0009 | 0.0008 | 0.0004 | 0.0015 |
| Bud Neck | 0.0026 | 0.0003 | 0.0007 | 0.0007 | 0.0004 | 0.0036 | 0.0008 | 0.0003 | 0.0015 | 0.0008 | 0.0011 | 0.0023 | 0.0025 | 0.0003 | 0.0006 | 0.0018 | 0.0008 | 0.0023 |
| Bud Periphery | 0.001 | 0.0028 | 0.0023 | 0.0009 | 0.0027 | 0.0004 | 0.0009 | 0.001 | 0.0023 | 0.0002 | 0.0048 | 0.0006 | 0.0013 | 0.0011 | 0.0009 | 0.0009 | 0.0004 | 0.0021 |
| Bud Site | 0.0023 | 0.0142 | 0.0036 | 0.0018 | 0.0001 | 0.0002 | 0.0055 | 0.0079 | 0.0054 | 0.0005 | 0.0014 | 0.0004 | 0.0067 | 0.0028 | 0.0011 | 0.002 | 0.0009 | 0.0003 |
| Cell Periphery | 0.0002 | 0.0003 | 0.0003 | 0.0001 | 0.0001 | 0.0001 | 0.0002 | 0.0002 | 0.0004 | 0.0001 | 0.0002 | 0.0001 | 0.0004 | 0.0002 | 0.0002 | 0.0004 | 0.0001 | 0.0001 |
| Cytoplasm | 0.474 | 0.631 | 0.6065 | 0.2277 | 0.5033 | 0.5923 | 0.5325 | 0.6884 | 0.6631 | 0.5887 | 0.3413 | 0.6276 | 0.4702 | 0.6532 | 0.6295 | 0.4998 | 0.6727 | 0.7128 |
| Cytoplasmic Foci | 0.0133 | 0.0083 | 0.0225 | 0.0151 | 0.0248 | 0.0127 | 0.0232 | 0.004 | 0.0125 | 0.0083 | 0.0302 | 0.0202 | 0.0255 | 0.0057 | 0.0044 | 0.0465 | 0.0034 | 0.0114 |
| Eisosomes | 0.0002 | 0.0001 | 0.0001 | 0.0003 | 0 | 0.0001 | 0.0002 | 0.0001 | 0.0003 | 0.0002 | 0.0002 | 0.0003 | 0.0003 | 0 | 0.0001 | 0.0004 | 0.0005 | 0 |
| Endoplasmic Reticulum | 0.005 | 0.0049 | 0.0054 | 0.0034 | 0.0036 | 0.0019 | 0.0062 | 0.0016 | 0.0036 | 0.0023 | 0.0095 | 0.0038 | 0.0081 | 0.0019 | 0.0028 | 0.0056 | 0.002 | 0.0044 |
| Endosome | 0.0119 | 0.0022 | 0.003 | 0.0211 | 0.0036 | 0.0032 | 0.0115 | 0.001 | 0.0051 | 0.0083 | 0.0278 | 0.0129 | 0.0323 | 0.0013 | 0.0021 | 0.0205 | 0.0016 | 0.0046 |
| Golgi | 0.0021 | 0.0002 | 0.001 | 0.0126 | 0.0002 | 0.0004 | 0.0034 | 0.0001 | 0.0025 | 0.0064 | 0.0068 | 0.0033 | 0.0115 | 0.0001 | 0.0002 | 0.0115 | 0.0019 | 0.0004 |
| Lipid Particles | 0.0028 | 0.0003 | 0.006 | 0.0079 | 0.0006 | 0.0019 | 0.0084 | 0.0002 | 0.0021 | 0.013 | 0.0198 | 0.0039 | 0.0106 | 0.0001 | 0.0002 | 0.0552 | 0.0012 | 0.0006 |
| Mitochondria | 0.0012 | 0.0005 | 0.0006 | 0.0042 | 0.0004 | 0.0003 | 0.003 | 0.0002 | 0.0017 | 0.0027 | 0.004 | 0.0019 | 0.0078 | 0.0003 | 0.0004 | 0.0049 | 0.0263 | 0.0011 |
| None | 0.4088 | 0.2891 | 0.2919 | 0.5924 | 0.3486 | 0.3086 | 0.3402 | 0.2686 | 0.2467 | 0.3131 | 0.4586 | 0.2334 | 0.331 | 0.2833 | 0.3155 | 0.3001 | 0.2326 | 0.1852 |
| Nuclear Periphery | 0.0086 | 0.003 | 0.0036 | 0.0056 | 0.0159 | 0.0059 | 0.0082 | 0.0017 | 0.0039 | 0.0028 | 0.0137 | 0.0107 | 0.0104 | 0.0025 | 0.0025 | 0.001 | 0.0014 | 0.0066 |
| Nucleolus | 0.0028 | 0.0003 | 0.0002 | 0.0002 | 0.0004 | 0.0005 | 0.0003 | 0.0001 | 0.0007 | 0.0021 | 0.0025 | 0.0003 | 0.0005 | 0.0001 | 0.0001 | 0.0003 | 0.0001 | 0.0003 |
| Nucleus | 0.0296 | 0.0328 | 0.0238 | 0.0286 | 0.0791 | 0.0573 | 0.0197 | 0.0183 | 0.0269 | 0.0222 | 0.0087 | 0.0404 | 0.0123 | 0.0395 | 0.0252 | 0.0042 | 0.0228 | 0.054 |
| Peroxisomes | 0.0017 | 0.0009 | 0.0142 | 0.0104 | 0.0005 | 0.0006 | 0.0087 | 0.0001 | 0.0014 | 0.0028 | 0.0197 | 0.0028 | 0.0066 | 0.0001 | 0.0002 | 0.0335 | 0.0075 | 0.0006 |
| Punctate Nuclear | 0.0102 | 0.002 | 0.0041 | 0.0034 | 0.0034 | 0.0056 | 0.0075 | 0.0013 | 0.0074 | 0.0189 | 0.0206 | 0.0088 | 0.0075 | 0.0021 | 0.0024 | 0.002 | 0.0008 | 0.0055 |
| Vacuole | 0.0029 | 0.0016 | 0.0014 | 0.0014 | 0.0061 | 0.0016 | 0.002 | 0.001 | 0.0037 | 0.0008 | 0.0024 | 0.0014 | 0.0023 | 0.001 | 0.0011 | 0.0015 | 0.0004 | 0.0014 |
| Vacuole Periphery | 0.0006 | 0.0002 | 0.0002 | 0.0006 | 0.0011 | 0.0004 | 0.0007 | 0.0001 | 0.0005 | 0.0003 | 0.0012 | 0.0007 | 0.0011 | 0.0001 | 0.0002 | 0.0005 | 0.0002 | 0.0004 |
Sequencing Data
| R1 | R2 | |||||||||
|---|---|---|---|---|---|---|---|---|---|---|
| G1 Post-START | S/G2 | Metaphase | Anaphase | Telophase | G1 Post-START | S/G2 | Metaphase | Anaphase | Telophase | |
| Gene Expression | 10.4274 | 3.3896 | 3.7729 | 1.1071 | 1.229 | 1.8948 | 10.7101 | 7.5177 | 5.4335 | 2.7215 |
| Translational Efficiency | – | – | – | – | – | – | – | – | – | – |
Hit Data
| Dataset | Hit |
|---|---|
| Protein Concentration | ✘ |
| Protein Localization | ✘ |
| Gene Expression | ✘ |
| Translational Efficiency | – |
Endocytosis
| Temp | Actin Patch (Sac6-tdTomato) | Cortical Patch (Sla1-GFP) | Late Endosome (Snf7-GFP) | Vacuole (Vph1-GFP) |
|---|---|---|---|---|
| 37℃ | ||||
| RT |
Cell Cycle Omics
CYCLoPs (Frm2-GFP)
| Gene / Allele | Actin Patch (Sac6-tdTomato) | Cortical Patch (Sla1-GFP) | Late Endosome (Snf7-GFP) | Vacuole (Sac6-tdTomato) |
|---|
| Gene | Images |
|---|
| Gene | Images |
|---|
Images are not yet available
Images are not yet available